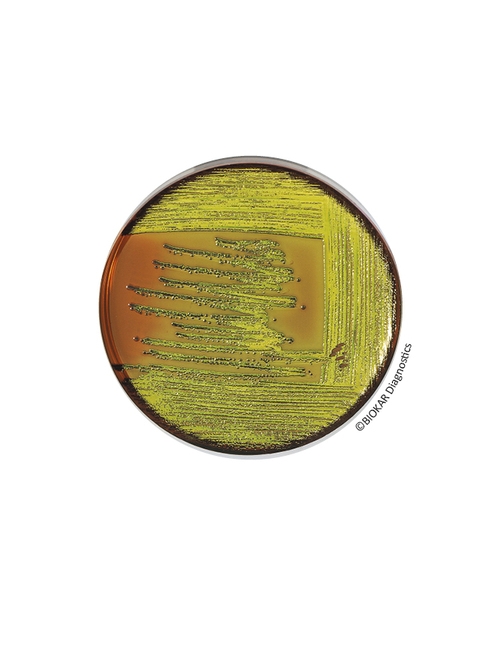
img

EMB Agar
EMB Agar Levine
Orijinal olarak Levine tarafından önerilen EMB Agar, suyun yanı sıra ilaç, kozmetik ve gıda ürünlerinde enterobakteri (özellikle Escherichia coli ve Enterobacter aerogenes) izole etmek ve tanımlamak için kullanılır. Ayrıca kozmetik ürünlerinde Escherichia coli için bir doğrulama besiyeri olarak da kullanılır.
Ürün Adı: EMB Agar
Ürün Kodu: BK056HA
Miktar: 500 g
